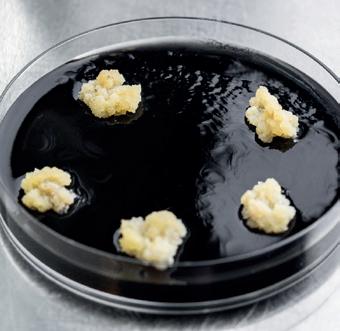

RESEARCH AND INNOVATION CENTRE



The Research and Innovation Centre (CRI) is part of the Fondazione
Edmund Mach, a major Italian institution operating in the agriculture, environment and food sectors.
The Foundation boasts 150 years of history. Established in 1874 as the Agricultural Institute of San Michele all’Adige, since 2008 it has been organised into three centres focussing on Research and Innovation, Education and Training, and Technology Transfer.
Seven hundred people now work on the 14-hectare campus equipped with classrooms, greenhouses, offices and laboratories, all outfitted with cutting-edge equipment. The Foundation also has 120 hectares of fields for experimental and agricultural purposes, plus 65 hectares of forest.

To guide the process of change towards a more balanced and harmonious development model for natural and agricultural ecosystems, reducing the impact of humans on the environment, and favouring biodiversity conservation, energy efficiency and the sustainable use of resources.
The Centre follows strategic lines that represent important challenges of our time, developing knowledge and technological innovation to improve sustainability in Alpine environments and agroecosystems.
To develop an interdisciplinary approach to manage the unique interactions within ecosystems for the global health and well-being of humans, livestock, wildlife and environment.
To study and incorporate digital technology for the automation and guided evolution of agricultural systems for sustainability purposes. To develop and use digital tools to deepen our knowledge of ecosystems. To integrate big data into digital platforms to monitor natural and agricultural ecosystems.
To generate and analyse large volumes of data using cutting-edge technologies. To apply mathematical, statistical and IT techniques for data integration, with the aim of a more holistic understanding of biological systems.
The Centre’s research activities converge on 4 main themes according to a matrix organization, with 21 Units and 21 technical facilities that interact and support each other, both transversally and synergistically.
Focuses on issues related to knowledge development for sustainable improvement of primary production and by-product use, with a view to promote a circular economy.

Studies and contributes to biodiversity protection by integrating basic and applied research. Promotes the sustainable use of agricultural and natural resources to balance the demands of modern societies with environmental protection.

This thematic area carries out research and innovation activities aimed at the sensorial, technological and nutritional enhancement of agrifood products, to improve their quality, guarantee their origin, and meet consumer needs.

This involves developing and applying various computational, bioinformatic and statistical modelling approaches to understand complex biological processes as well as the interactions between organisms and their environment.

In national and international scientific landscapes, the Centre is noted as multidisciplinary and transversal while its highly skilled researchers address research topics by integrating micro and macro approaches.
Berry Genetics and Breeding
Bioeconomy
Digital Agriculture
Fruit Crop Genetics and Breeding
Grapevine Genetics and Breeding
Plant Biology and Physiology
Plant Biotechnology
Plant Epigenetics
Plant Protection
Animal Ecology
Applied Ecology
Conservation Genomics
Ecogenomics
Environmental Botany
Forest Ecology
Hydrobiology
Biotechnology of Natural Products
Metabolomics
Sensory Quality
Traceability
Computational Biology
Approximately 300 people, including researchers, technologists, technicians, PhD students and visiting scientists, are dedicated to research. They are coordinated by the Scientific Director and supported by administrative staff. The average age of this team is 46; 13% are non-Italian, while 43% of the Research Unit leaders are women.

Aerobiology Animal, Environmental and Antique DNA

Development of Biofungicides and Biofertilizers



Hydrochemistry
Quarantine

Remote Sensing

Bio-logging
Biomasses
Biotechnology of Fermentation
Biotremology
Computational Biology
Hydrochemistry
Metabolomics

Microfluidics, Microdissection and Microscopy



Micrometeorology
Plant Phenotyping



Plant Tissue Culture
Sensory Analysis
Sequencing and Genotyping Traceability





Sensing Traceability


Varietal Identification and Grapevine
Germplasm Valorization
Volatile Organic Compounds Analysis
We invest considerable time and resources in training the researchers of tomorrow. Since 2010, our Doctoral Program has been active and has trained 240 PhD students so far. More than 50 partners, including universities and private companies, support this program. Its quality is guaranteed by participation in the European initiative Euraxess - Researchers in Motion.
80%
Eighty percent of our postgraduates have stated they were employed in prestigious research institutions or universities within two years of graduation.
Every year our researchers publish more than 200 articles in peer-reviewed scientific journals.
The quality of research has also been demonstrated by the excellent placement of Fondazione Edmund Mach among all institutions evaluated by the Italian National Agency for the Evaluation of University and Research Institutes (ANVUR).
BIOLOGY
3°/75
RANKING OF FONDAZIONE EDMUND MACH AMONG ITALIAN RESEARCH INSTITUTIONS (2015-2019)

AGRICULTURAL AND VETERINARY SCIENCES

7°/39
CHEMISTRY
18°/65

Financial resources arise from public funding, contracts and agreements with other institutions and companies, as well as from research projects funded by third parties.
The high success rate in awarding tenders suggests that the Centre is recognised nationally and internationally as a prestigious, reliable and charismatic partner for high quality research.
(excluding NRRP funds)
475 contracts signed for a value of ca 25 Mln € ca 7,2 Mln €
The Centre plays a leading role in planning the NRRP, participating in many activities, including the following four initiatives.
1 2
Research and development of innovative technologies in the agricultural sector to improve the quantity and quality of production, ensuring sustainable adaptation to climate change. FEM will focus on production improvement through crop breeding in response to new health emergencies, climate change and related stressors, also exploring genetic resources to develop new varieties that are resilient and adaptable to changes.
To monitor, preserve and restore functional biodiversity to mitigate the impact of human activities and climate change, and to support ecosystem services. FEM will use innovative field and laboratory-based approaches to study the biodiversity of Alpine ecosystems - from lakes and rivers to forests, alpine meadows and boreal zones - and across taxa: from microorganisms to trees and herbaceous plants, as well as invertebrates, fish, amphibians and large and small mammals.
3 4
To develop and validate strategies for preventing waste, increasing the sustainability, circularity and security of supply chains, while at the same time, improving the quality of consumer diet and nutrition. FEM will apply new technologies for food quality and safety, processing novel functional foods and testing their quality and consumer acceptability.
To rapidly enhance and extend the benefits of digital technologies to northeastern Italy in the key areas of manufacturing, agriculture, sea, mountain, construction, tourism, culture, health and nutrition. FEM will promote the digitisation of agronomic practices, the identification and development of decision support systems, and sustainable practices for the agricultural supply chain in a circular economy context.
RUSSIA: 1
ASIA: 16
CANADA: 4
USA: 34
SOUTH AMERICA: 8
AFRICA: 6
AUSTRALIA: 3
NEW ZEALAND: 4
A tight network of research collaborations (Italian, European, and international) to work in synergy.
Over 570 organizations and companies collaborate in multiple ways with the Centre.
RESEARCH AND INNOVATION CENTRE
Via Edmund Mach 1
38098 San Michele All’Adige (TN) - Italy
www.cri.fmach.it/en